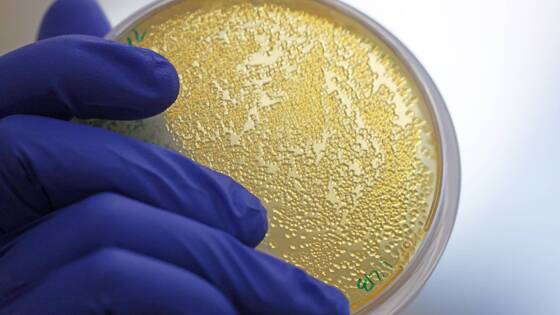

Создан новый класс антибиотиков, атакующих клеточные стенки бактерий
Ученым удалось выяснить, что короткая молекула JEDI-852 эффективно уничтожала микробов, но при этом не убивала человеческие клетки даже в относительно высоких концентрациях
Европейские биохимики создали две коротких молекулы, блокирующих работу бактериального фермента LpxH, который играет ключевую роль в процессе сборки клеточных стенок большого числа болезнетворных микробов. Новые антибиотики были успешно проверены в опытах на мышах, сообщила в понедельник пресс-служба шведского Университета Уппсалы.
"Главная особенность этого класса лекарств заключается в том, что ни один другой антибиотик не атакует белок LpxH, в результате чего у микробов еще не возникла стойкость к их действию. Это отличает данные соединения от многих других новых антибиотиков, схожих по устройству и функциям с уже существующими молекулами, и делает их особенно перспективными для проведения дальнейших клинических испытаний", - говорится в сообщении.
Открытие было совершено группой шведских и датских биохимиков под руководством научного сотрудника Университета Уппсалы Дугласа Хасби при изучении действия различных коротких молекул, уже созданных биологами и химиками, на культуры клеток грамотрицательных бактерий. К их числу относятся возбудители пневмонии, болезни легионеров, кишечных заболеваний, сальмонеллы и большого числа других опасных болезней, в том числе "иракская палочка" и менингококк.
В ходе этих опытов ученым удалось выяснить, что короткая молекула JEDI-852 эффективно уничтожала микробов, но при этом не убивала человеческие клетки даже в относительно высоких концентрациях. Последующее изучение ее структуры и свойств показало, что она блокирует работу фермента LpxH, отвечающего за сборку молекул липосахаридов, одного из ключевых компонентов внешней оболочки грамотрицательных бактерий.
Исследователи изучили, как это вещество взаимодействовало с ключевой частью белка LpxH, и использовали эти сведения для создания нескольких новых вариаций вещества JEDI-852 с более высоким уровнем противомикробной активности, стабильности и биодоступности. Действие двух самых перспективных молекул, получивших имена EBL-3647 и EBL-3599, биохимики проверили в опытах на мышах.
В ходе этих экспериментов исследователи заразили грызунов неуязвимыми штаммами кишечной палочки и возбудителя пневмонии (Klebsiella pneumoniae) и попытались предотвратить развитие сепсиса при помощи EBL-3647 и EBL-3599. Инъекции относительно небольших количеств этих веществ защитили грызунов от заражения крови, что говорит о высокой перспективности этого нового класса лекарств.
О растущей стойкости бактерий к антибиотикам
За последние два десятилетия биологи зафиксировали появление нескольких десятков штаммов микробов, стойких к действию одного или сразу нескольких антибиотиков. Эти "супербактерии" возникают как в результате массового нецелевого использования антибиотиков в медицине и животноводстве, так и в результате попадания лекарств вместе с городскими и промышленными стоками в природные экосистемы.
Многие из них, в том числе туберкулезная палочка, золотистый стафилококк и пневмококк, сегодня вызывают вспышки "больничных" инфекций, с которыми становится все сложнее бороться. Подобные проблемы вынуждают ученых ускоренно создавать новые антибиотики и вырабатывать новые стратегии их применения, снижающие шансы на появление новых "супербактерий".